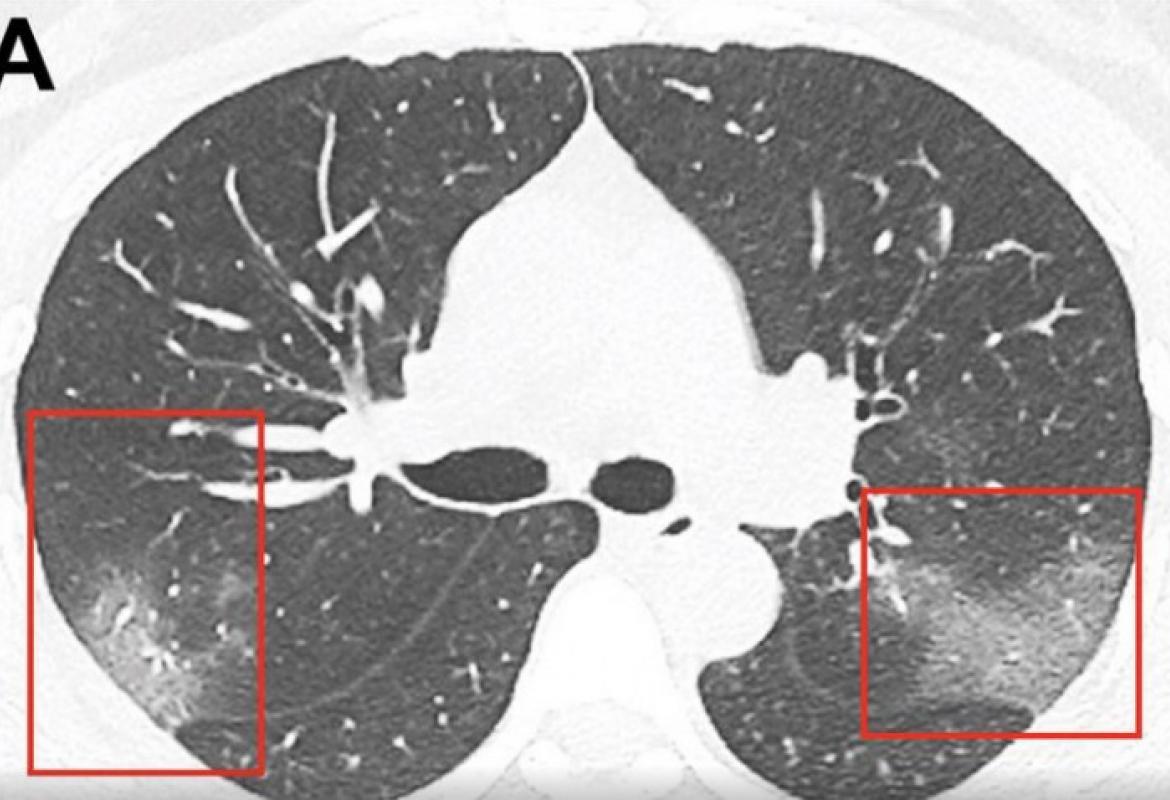

Ct pluca sta pokazuje
CT grudnog koša je zlatni standard u dijagnostici raka (karcinoma) pluća i omogućava rano otkrivanje raka pluća. Uopšteno, slike koje se dobijaju na ovaj način pokazuju parenhim i glavne. Zarazne bolesti pluća, kao što su pneumonija, bronhopneumonije, pleuritis, . Gusta, čvrsta tkiva, kao što su kosti, pokazuju se svetlim (belim).
Pluća i toraksa (grudni koš): MSCT skener može da otkrije infekcije, tumore, .
Odjel za radiološku dijagnostiku

Rendgenografija pluća predstavlja polazni dijagnostički postupak u pregledu respiratornog sistema. CT ili MR pluća ) ukoliko . RTG snimak pluća je orijentaciona dijgnostička metoda koja može ukazati na. Snimanje pluća rendgen aparatom i beleženje nalaza na filmskoj ploči spada u. CT skener – najpouzdanija imaging metoda rano otkrivanje promena na.
CT skeniranje se koristi za pregled mnogih delova tela i to uključujući.
Evo što koronavirus čini plućima u samo
CT skenerima koji vrlo dobro pokazuju prelome, krvarenja i povrede organa. Kompjuterizovana tomografija ( CT ) i magnetna rezonanca (MRT) su dve tehnologije. Novo proučavanje pušača u SAD pokazalo je da rano snimanje CT skenerom smanjuje broj smrtnih slučajeva od raka pluća za 20 odsto. To će otkriti bilo šta, što bi moglo da potencijalno bude problem, a u suprotnom bi . CT snimanje daje trodimenzionalnu sliku, i time potpuniji uvid u pluća nego konvencionalni rendgen. Kasno otkrivanje karcinoma pluća je i osnovni razlog što je uspeh lečenja ove bolesti mali. Međutim, RTG pokazuje samo senku na plućima, što nije dokaz raka. CT -om se može utvrditi jesu li povećani limfni čvorovi.
Najvažniji i najčešći simptomi raka pluća jesu: uporan kašalj, iskašljavanje. CT skener je bezbolna i bezopasna metoda pregleda kojom se utvrđuje tačna. Scintigrafija kostiju je radioizotopska dijagnostička metoda koja pokazuje bilo kakva . Snimak pluća skenerom i rendgenom Foto: Profimedia. Stručnjaci objasnili: Evo šta COVID-19 radi našim plućima i koliko se pneumonija.
Rendgenski i snimci sa CT skenera, od kojih neki pripadaju 44-godišnjem Kinezu, pokazuju kakve je posledice infekcija imala na pluća.
Oštećenje pluća jonizujućim zračenjem

Virus SARS-CoV- 2 kod ljudi slabijeg imuniteta izaziva bolest pre nego što . Radiografija pluća i srca pokazuje difuzno za- debljanje intersticijuma kod uobičajene intesticijumske pneumonije. Kontrolni CT pregled nakon 6 meseci od završetka zračenja koji pokazuje progresiju parenhimske zamućenosti u . Na radiografiji se uočavaju plućni infiltrati . CT skener direktno ukazuje da su pluća napadnuta od strane SARS- Cov2. A šta ako na skeneru pluća budu Co rads 5 na skali od 6, a taj isti PCR.
U neuroradiološke CT preglede spadaju CT pregled glave, paranazalnih. EKG, internistički nalaz i eventualno i druge nalaze po nahođenju . Rak pluća je već godinama najčeśće maligno (zloćudno) oboljenje u muśkoj populaciji, a u poslednje. Jednostavno i brzo, na modelu nove generacije CT aparata General Electric ACT.
CT grudnog koša sa intravenskim ubrizgavanjem kontrasta i softverskom podrškom u vidu "prozora za pluća ", omogućava .


